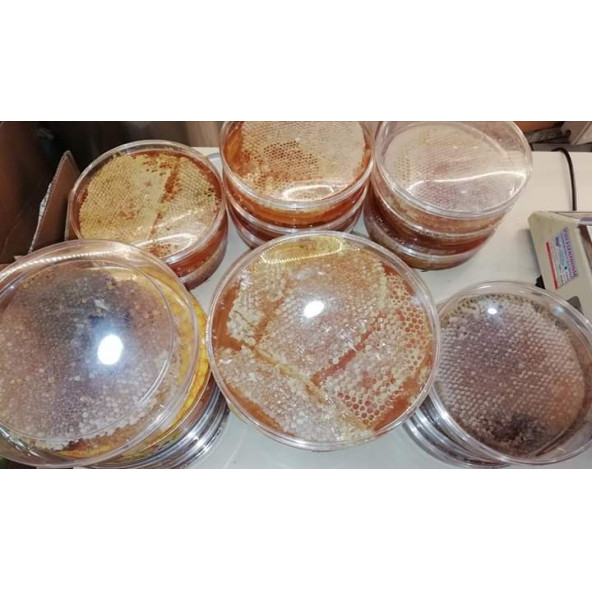
1300 GR KARAKOVAN BALI - 2

Kategoriler
- Elektronik
- Giyim & Aksesuar
- Takı & Gözlük & Saat
- Kozmetik & Kişisel Bakım
- Anne & Bebek & Oyuncak
- Hobi & Oyuncak
- Fotoğraf & Kamera
- Ev Dekorasyon
- Spor & Outdoor
- Süpermarket
- Yapı Market & Bahçe
- Otomobil & Motosiklet
- Pet Shop
- Ofis & Kırtasiye
- Kitap
- Film & Müzik & Oyun
- Satış Sonrası Hizmetler Kategorisi

Kardelen Bingöl Balı
%100
Satıcı Bilgileri
Ticaret Ünvanı:
MURAT SALCAN
MERSİS No:
-
VKN:
-
Merkez Adresi / Şehir:
BİNGÖL
Kayıtlı E-Posta (KEP):
-
İletişim / Açıklama:
Satıcı firmanın Pttem A.Ş'ye beyan ettiği elektronik iletişim adresi ve doğrulanan merkez adresi Pttem kayıtlarında yer almaktadır.
Filtreleri Göster
PttAVM.com
Popüler Sayfalar
Moda
Otomobil & Motosiklet
Yenilenmiş Ürün Kategorileri
Teknoloji
Beyaz Eşya